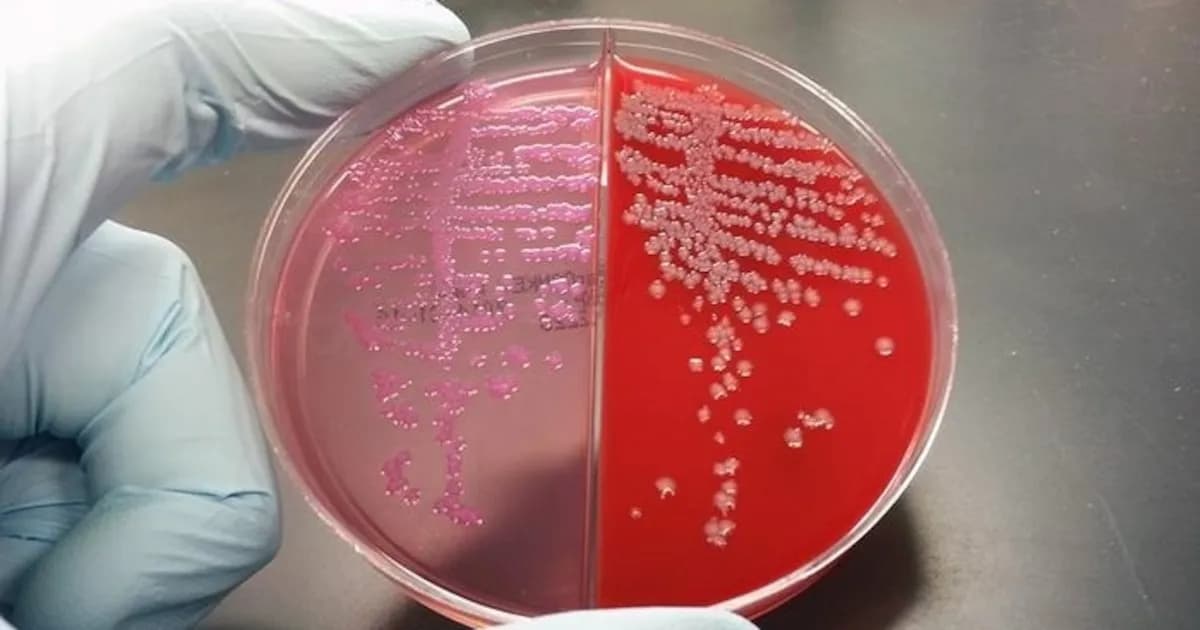
Descubren virus en bacterias intestinales que podría relacionarse con el cáncer de colon

Un nuevo hallazgo en la microbiota intestinal sugiere que un virus desconocido podría abrir nuevas líneas de investigación sobre el cáncer colorrectal, uno de los más prevalentes a nivel global. La investigación se centró en la interacción entre la bacteria Bacteroides fragilis y un bacteriófago específico, lo que ha llevado a los científicos a examinar su posible vínculo con el desarrollo de tumores.
Hasta ahora, se había observado que Bacteroides fragilis es común en personas sanas, pero también se presenta con frecuencia en aquellos diagnosticados con cáncer colorrectal. En España, según la Sociedad Española de Oncología Médica (SEOM), se estima que 30.035 nuevos casos de cáncer de colon serán diagnosticados este año. Sin embargo, la razón detrás de esta asociación había permanecido sin respuesta.
El estudio, realizado por un equipo de investigadores de Dinamarca y Australia y publicado en la revista Communications Medicine, reveló que la clave de esta relación radica en la presencia de un virus asociado a la bacteria. Utilizando técnicas avanzadas de secuenciación genética, los científicos analizaron muestras de bacterias intestinales de pacientes con cáncer colorrectal. Los resultados mostraron que aquellos con la enfermedad tenían el doble de probabilidades de portar el bacteriófago en comparación con los sanos. Aunque se ha establecido este vínculo, los autores advierten que todavía no se ha demostrado una relación causal entre el virus y el cáncer, lo que abre un campo de estudio para futuras investigaciones.